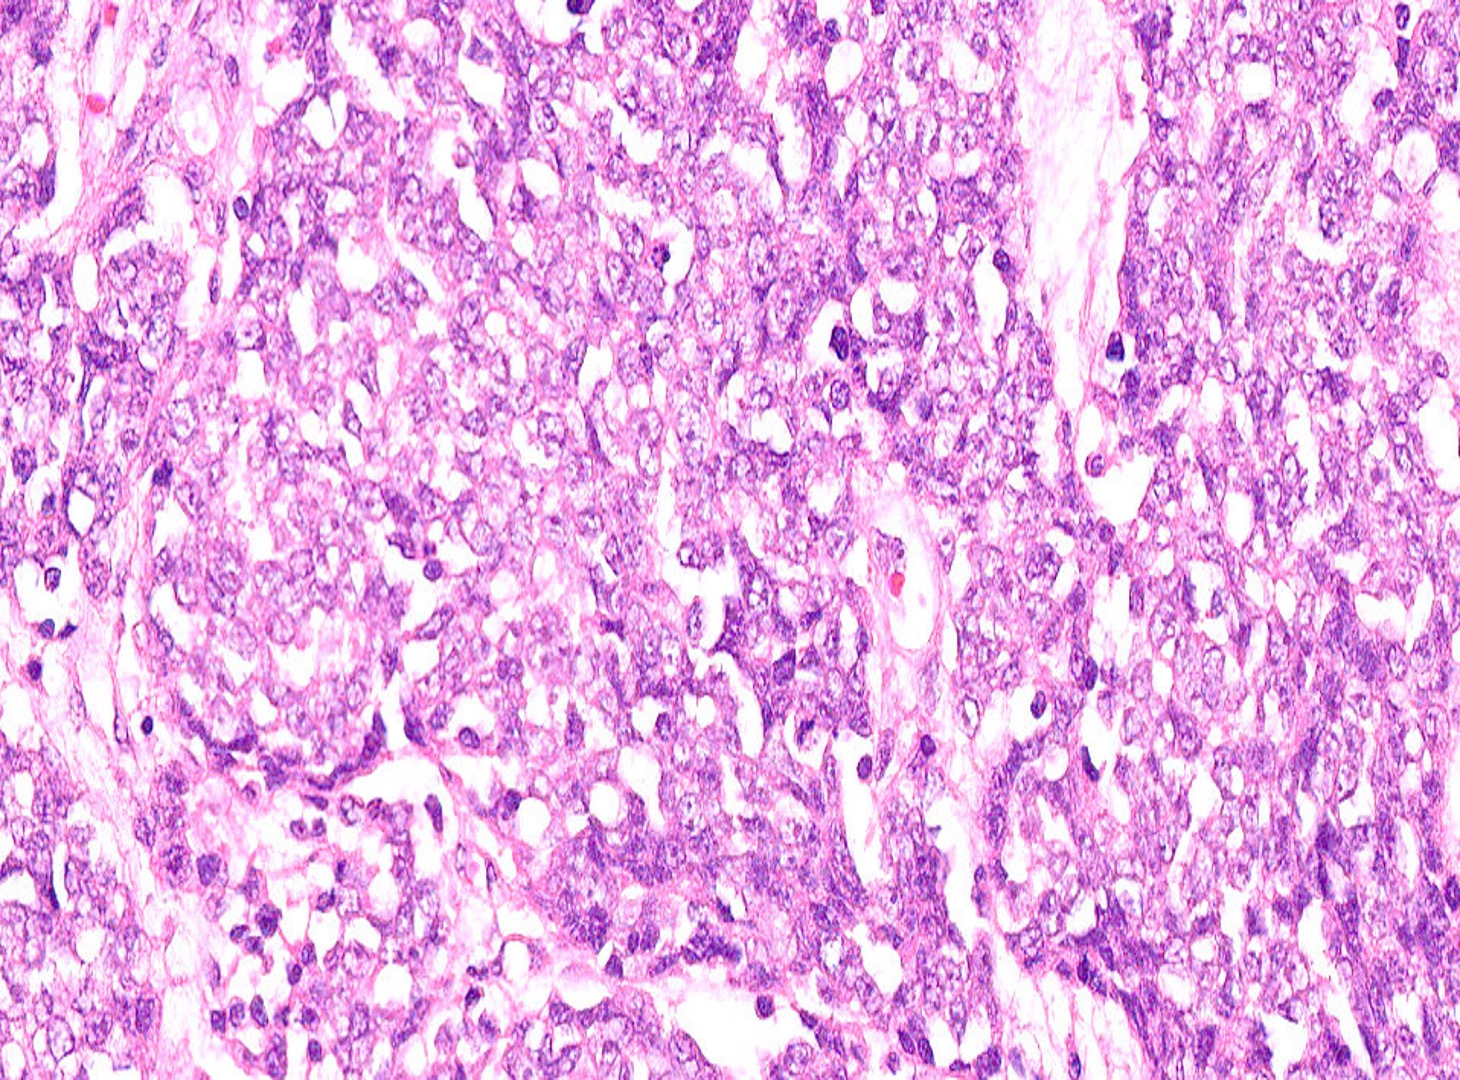

Case Study #5
March 2026 - 34 year old female non-smoker
The patient, a 34 year old female non-smoker, social drinker, reports a dry, non-productive cough that began approximately six weeks ago and has gradually worsened. She also notes intermittent right-sided chest discomfort not associated with exertion. Over the past two weeks, she has developed mild shortness of breath on exertion and reports a 10-pound unintentional weight loss. There is no history of fever, hemoptysis, or recent upper respiratory illness. She denies night sweats but reports fatigue. Chest x-ray shows right upper lobe opacity, and chest CT shows a 4 cm spiculated mass in the right upper lobe with mediastinal lymphadenopathy and no pleural effusion. A subsequent PET scan indicates a hypermetabolic right upper lobe mass with mediastinal lymph node involvement; no distant metastases.
A full-thickness biopsy of the lesion was taken.
What is the diagnosis?

Pulmonary Pathology
Pulmonary Pathology